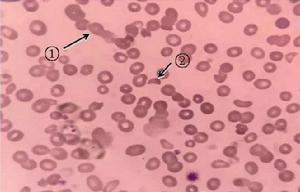
血塗片製作

基本原理
將一小滴血液均勻塗在玻片上,呈單層分布,製成薄血片。用瑞氏染液進行染色。細胞中的鹼性物質,如RBC中的血紅蛋白及嗜酸性粒細胞嗜酸性顆粒等與酸性染料伊紅結合染成紅色;細胞中的酸性物質,如淋巴細胞胞質及嗜鹼性粒細胞質中的嗜鹼性顆粒等與鹼性染料亞甲藍結合染成藍色;中性粒細胞的中性顆粒呈等電狀態與伊紅和亞甲藍均可結合,染成淡紫紅色。
載玻片的要求
製備血塗片使用的載玻片要有很好的清潔度。新的載玻片常有游離鹼質,套用清洗液或10% 鹽酸浸泡24小時,然後再徹底清洗。用過的載玻片可放入適量肥皂水或洗滌劑的水中煮沸20分鐘,再用熱水將肥皂和血膜洗去,用自來水反覆沖洗,然後擦乾備用。
操作步驟
1、用毛細吸管吸取EDTA抗凝的外周血5-7UL,或者直接採集患者末梢血,將血滴滴至載玻片的一端約1CM處或整片的3/4端。有磨砂片的玻片,可在接近磨砂頭的部位來水反覆沖洗,然後擦乾備用。
2、左手持載玻片,右手持玻片,將推片接近血滴處,然後輕輕接觸血滴並壓在血滴上,使血液呈“ ̄”字型展開,充滿推片寬度。
3、將推片與載玻片形成30度夾角,用均勻的速度將血向載玻片的另一端推動。紅細胞壓積發生變化時,應適當的調整推片與載玻片的角度以及推動血液是的速度。標準的血塗片應做到頭、體、尾分明,兩邊和兩端留有空隙。
染色方法
1、瑞氏-吉姆薩混合染色能集合瑞氏染色與吉姆薩染色的優點。
2、染色方法:標記血塗片,將血塗片平放在染色架上,滴加A液覆蓋整個血膜,30秒-1分鐘後,滴加B液,將A、B液混勻,可用洗耳球輕吹液面,A、B液的比例為1:2,靜置水平位置染色5-10分鐘後,將載玻片拿起,輕輕晃動,使染料不再附著於血膜上。把水流調至最小,平持載玻片,與水流方向呈90度,在血膜頭部沖入,向血膜的尾端調整玻片的角度,直至染料沖乾淨,沖洗乾淨後的血塗片,放置在血片架上將水自然控乾,或傾斜玻片等待自然乾燥。
3、判斷染色結果:在正常情況下,良好的染色結果為血膜外觀為淡紫紅色;低倍鏡下,細胞分布均勻;細胞呈粉紅色,少見染色顆粒,白細胞胞質能顯示各類細胞的特有色彩,白細胞核染成紫紅色。